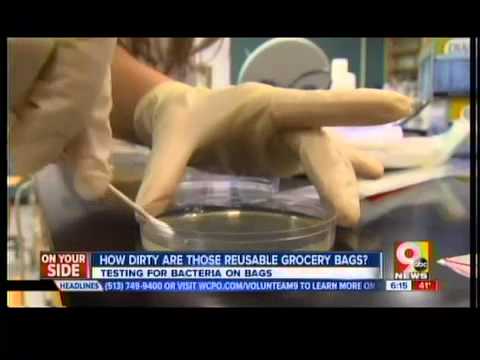

Posted on 09/30/2014 9:50:39 AM PDT by Oldeconomybuyer
Gov. Jerry Brown has signed legislation imposing the nation's first statewide ban on single-use plastic bags.
Plastic bags will be phased out of large grocery stores starting next year and convenience stores and pharmacies in 2016. The legislation is meant to encourage consumers to bring their own bags and as a way to reduce litter.
(Excerpt) Read more at abcnews.go.com ...
Stupid....
....But it’s California, so this isn’t at all surprising.
Enjoy your e-coli, Cali.
Another brilliant, absolutely brilliant, action by a brilliant, intellectual, loving, caring, all-knowing progressive genius.
Absolutely brilliant!!!
/s/
IMHO
E-Cali
It’s real annoying. You have to carry your own bag to the grocery store, or pay money for them to give you a bag. Now I just buy plastic bags, so it’s not like there’s less plastic in the world.
I live in a stupid state.
I already have a bunch of Trader Joe’s cloth or reusable bags. I’d rather use those and already do — but I don’t need the government to tell me!
What will they do with pilosi? That plastic bag has been around for years.
whatever happened to Save a Tree..use a Plastic Bag???
what about plastic GARBAGE BAGS??? what will they be replaced by?
Reusable canvas bags arent gonna work out that well for that purpose....
I am old enough to recall what trash day was like before the advent of plastic bags.
A smelly, oozing, fermenting, unsanitary mess.
Plastic bags have made one of the single greatest contributions to public health in this country.
How about styrofoam coffee cups?
All hail the communists capital of America CALIFORNIA!
idiots. I remember when CA was pushing so hard FOR plastic bags back in the late 70’s early 80’s because paper bags were killing all the trees and plastic was “renewable”!
Will they test those home bags for dog feces and cat urine? Maybe after there is some weird disease going around and someone decides to test the home bags for dog feces and cat urine.
So, I wonder if people can use their own plastic bags from home that they know are clean?
Just goes to show you how stupid California is.
What gets me about this, is that nobody talks about why it is we have plastic bags in the first place.
The reason we have plastic bags is because a previous generation of liberals pushed them in the early ‘80s due to wanting to save trees and save the rainforests. They wanted us to use plastic bags so they could save trees.
Now the liberals have changed their minds about plastic bags. Now they want to ban them. But they have never admitted they were wrong to have foisted plastic bags on us in the first place.
Were they wrong then or are they wrong now?
“How often are those home bags washed? Never.”
And the reason they are never washed is, half the time they fall apart in the washer.
Yeah, those ‘reusable’ canvas bags are nearly useless if someone is buying groceries for more than a day or two. Especially for those with larger families.
Paper bags SUCK. The plastic bags work the best. They can hold a good amount of items, and are handy to use around the house for other things.
This rule is gonna make shopping at Wal-Mart a nightmare!(worse than it is already!) I expect this may bring about a backlash from the citizens, but being California, they probably have a high tolerance for stupidity like this.

Disclaimer: Opinions posted on Free Republic are those of the individual posters and do not necessarily represent the opinion of Free Republic or its management. All materials posted herein are protected by copyright law and the exemption for fair use of copyrighted works.